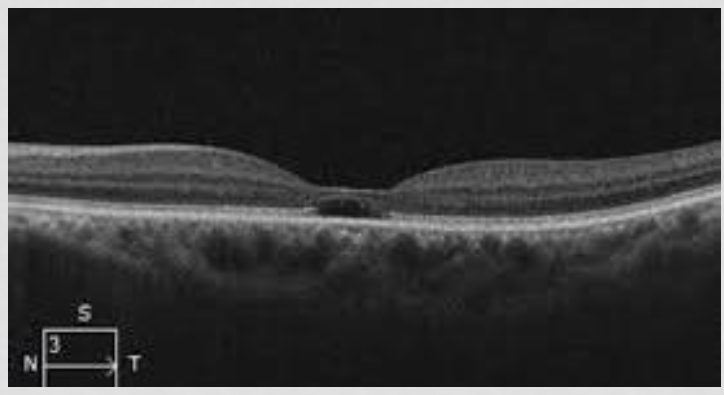
<p>outer retinal cystic formation → <strong>Macular cavitation</strong>; empty space/cavity with NO fluid</p><p>IZ gone; lost RPE and outer photor</p><p>EZ gone; loss of outer and inner photo r</p><p>damaged photor/RPE → decrease liposuscin</p>

Exam 2
1/35
There's no tags or description
Looks like no tags are added yet.
Name | Mastery | Learn | Test | Matching | Spaced | Call with Kai |
|---|
No analytics yet
Send a link to your students to track their progress
36 Terms
Case 6 demographic
40 y/o caucasian male works as pilot; decreased vision OU
progressive for last 3m; constant and occasional itching
Hx: LEE 1 year ago, nasal allergies, uses lubricants and Patanol when needed, allergies to pollen
FHx: HTN with mother and father
BCVA: 20/70 OU with +0.25D
confrontation fields: FTFC; central scotoma on facial Amsler
CV: mild B/Y defect
SLE: trace hyperemia, papillae +1; every thing else normal
fundus: yellow/white foceal lesions with dark around it

DDx case 6
Bulls eye maculopathy; Chloroquine/Hydroxy/Plaqenile (not taking meds), Stargerdts (presents at younger age), Cone-rod (presents at younger age
Macular cysts: sacular yellow lesion; need OCT, FA, FAF
FA: inject Fl and see pathology of vessels (hyper → leakage and window defect)
FAF → autofluorescence of melanin and lipofuscin (hyper → alot of lipofusin and little melanin; hypo → little lipofuscin/alot of melanin)
Our pts OCT
outer retinal cystic formation → Macular cavitation; empty space/cavity with NO fluid
IZ gone; lost RPE and outer photor
EZ gone; loss of outer and inner photo r
damaged photor/RPE → decrease liposuscin
Our pt FAF
hypo macula ; loss of lipofuscin
damaged production of lipofuscin = damaged RPE

Out pts FA
early hyper
small window defect; loss of RPE/photor, can see through it

Disease causing macular cavitation/cysts in outer retina
cone-rod dystrophy; congenital
achromatopsia; congenital, complete color blind and damage retina
mac tel 2 → neurodegeneration, cavitation of inner/outer layers, fundus different
solar maculopathy; acute phototoxicity, hypo FAF, hyper FA (our dx; pilot)

Mac tel 2 findings (Slide 14-17)
parafoveal grey/green; retinal thinning and decrease melanin
telangiectasia in fundus; vessels go into macula and bend at 90 degrees
crystalline deposits (damaged Muller cells); effects outer and inner layers
hyperplasia of pigment
OCT: inner cavitation most common; ILM drap sign; can have outer cavitation
FAF: hyper parafovea, thin retina and decrease melanin
FA: telangiectasia leakage

Solar maculopathy (case 6 Dx)
acute: damage to IZ/EZ/RPE
chronic: months passes, RPE regenerates, EZ does not (damage to photor still)
VA 20/25-20/100; depends on damage to photor and which ones effected
increase damage of inner photor → worse VA (if most of the damage is in outer photor, the VA is better)
Prognosis: good/guarded; most recovers vision in 3-6m (depends on damage and which photor effected)
recovery also depends on initial VA loss; worse VA loss needs more time to recover
Tx: no specific Tx may give antioxidants to decrease oxidative stress
steroids could decrease inflammation of the macula; but could cause CSCR bc photor already damage (being studied but issue is CSCR)
Case 7 demo
47 y/o caucasian female; secretary; wrinkled distorted vision OU
OS>OD, mild to mod, progressive for one year, constant and worse with time
Hx: LEE 2 years ago, reading glasses, HTN, myotonic dystrophy type 1
previously told had “aging changes” of retina
meds: Lisinopril
ROS: fatigue, progressive lower extremity weakness
BCVA: OD 20/25-1, OS 20/40-2
controntation: FTFC, some distortion in facial amsler
SLE: mild hyperemia, trace papillae,
Case 7 posterior exam
macula: absence of foveal reflex with pigment clumping OU
strange changes in macula
was told pt had aging changes; but our pt is 47 (too young for AMD)

Case 7 auxillary tests
OCY
FAF
FA
Case 7 OCT
OD: ERM present, depositons on RPE, disruption of EZ/IZ/RPE
OS: macular pitt (missing layers)/partial lamellar hole (inferferes with inner layers only, outer layers normal), photor diruption

Case 7 FAF
hyper OU; increased lipofuscin
due to RPE issue; doesn’t get rid of waste and it accumulates

Pattern macular dystrophies
AD inheritance; kids may inherit a different form of pattern dystrophy
bilateral RPE proliferation with increase lipofuscin, okay VA
may have a typical presentation to differing types in each eye
4 types
Looks like AMD at a younger age; mimics other hereditary conditions
Diagnosis
OU Adult vitelliform pattern macular dystrophy; butterfly type
OD: ERM
OS: Lamellar hole
Adult vitelliform pattern macular dystrophy; butterfly type etiology
Retina degeneration slow (RDS) gene
produces peripherin 2 protein; responsible for maintaining photor disc
with pattern dystrophy: gene mutated → less protein → less photor disc maintenance → RPE gets sick → accum lipofuscin
system disease associated to Adult vitelliform pattern macular dystrophy
butterfly pattern type → myotonic dystrophy
all types (mostly fundus pulverulentus/FP) → pseudoxanthoma elasticum
Reticular pattern dystrophy (RPD)
net like pigmentation
most symmetric of all types
ERG: normal/mild decrease
EOG: normal/mild decrease

Macular pattern dystrophy simulating fundus flavimaculatous (MPDSFF)
actual fundus flavimactous → dark choroid, poor VA
pattern dystropht → bright white areas of choroid, VA still good, brighter surrounding area with no dark choroid
ERG: normal/slightly decreased (true fundus flavimaticus/stargardts decrease ERG)

Adult onset foveal vitelliform pattern dystrophy (AOFVPD)
mimics best in adults
yellow egg yolk of macula
older patients, better VA
ERG: normal or slightly decreased
EOG: barely effected; normal/slight decrease (best has decreased EOG)

Fundus pulverulentus (butterfly)
looks like AMD in younger pts; symmetric btwn eyes
no drusens present
diffuse RPE clumping
ERG: normal or mild decrease
EOG: normal or mild decrease

Pattern dystrophy management
some may progress; butterfly type worsens with age (decrease vision and CNVM)
if 70 y/o with pattern dystrophy; must also check for AMD (hard to decipher), monitory for atrophy of AMD (OCT, FAF)
monitor and f/u with all types (butterfly type; monitor for CNVM)
can give antioxidants bt cannot prevent progression
Case 8 demo
76 y/o caucasian male, retired, bothersome pain in OS started last night and gotten worse (unbearable); very severe and sudden (14 hours ago)
vision very blurry; HA, nausea, vomiting
ocular Hx: phaco Sx with IOL OU 5 years ago, YAG capsulotomy OS 8 months ago, another laser in OS 10 years ago doesnt remember; LEE 8m ago
medical Hx: hypothyroid, depression, chronic pain; Synthroid, Trazadone, Tramadol
ROS: chronic pain and uses narcotics (Tramadol)
BCVA: OD 20/25-1, OS 20/70-2
pupils: OD 3.5mm in dark 2mm in light; OS 5mm in light and dark; +2 APD OS
Confrontation: FTFC OS, generalized constriction OS
SLE exam case 8 (slide 7 and 8)
lids/lashes/adnexa → MGC 2+
conjunctiva: hyper +1 OD, hyper 2+ OS
A/C: deep/quiet OD, OS look at image
patent LPI in OS (laser Sx pt couldn’t remember)
IOPs: OD 11, OS 52
gonio: OD SS seen in all quadrants, OS ant TM and SL seen 360 (closed)

case 8 fundus
OD: 0.55/0.55, negative FR, RPE changes, post pole healthy, no breaks/detachments
OS: 0.85/0.85, notching, negative FR, RPE changes, post pole healthy, no breaks/detachments
Additinal tests for case 8
anterior chamber OCT
anterior chamber B scan
Case 8 anterior chamber OCT
normal curvature of the iris
angle closed the whole way (periphery and central)
no iris bombe

Case 8 anterior B-scan
normal curvature of the iris
angle closed the whole way (periphery and central)
no iris bombe

DDx for case 8
primary/pupillary block angle closure glaucoma : LPI will always work; pupillary block with iris bombe (central A/C is open and periphery is closed)
secondary: LPI will NOT work, central and peripheral A/C is closed
Aqueous misdirection syndrome (our Dx)
must r/o tumors (push everything forward), choroidal detachment
testing for primary/pupillary block angle closure
iris bombe (convex iris)
open centrally and closed peripherally
NOT OUR DX

Aqueous misdirection syndrome (malignant glaucoma); secondary closure
closed central and peripheral; everything pushed forward
after Sx, AH escapes anterior chamber and goes back behind vitreous and pushes vitreous forward
too much volume overload in posterior chamber; creates pressure in front of eye (complete closure of center and periphery)
Treatment for aqueous misdirection syndrome
decrease pressure by medications that decrease AH production; B blockers, CAIs, Adrenergic agonist
decrease vitreous volume; dehydrate the vitreous with hypertonic solutions (Mannitol and Glycerol)
Push iris back with cycloplegics (cyclo and atropine); dilating pupil releases the iris and allows relaxing/moving back (stops accommodation)
CANNOT USE PILOCARPINE (will worsen)
if medications dont work (50% pts) → laser with Sx
Surgeries/laser for misdirection
try meds first: cycloplegia, AH suppressants, osmotic agents, steroids
phakic pt: cataract extraction with IOL impantation → posterior capsulotomy and disruption of anterior hyaloid → vitrectomy
pseudo/phakic: ND: YAG capsulotomy and disruption of anterior hyaloid → trans-scleral cyclodiode laser → vitrectomy
Complications of AH misdirection
peripheral anterior synechiae
corneal edema and decompensation; due to damage
accelerate cataract formation/progression in phakic pts
myopic shift; everything shifted forward but NOT the retina
retinal or choroidal detachments
macula detachment
Prognosis of AH misdirection
good-guarded; many treatment options
recurrent; second resentation is 2x harder to treat
other eye has 75-80% likely to get malignant glaucoma as well
prophylaxis for other eye is cycloplegics, cataract Sx, wait to see if anything happens (laser if anything happens)
three steps → Tx one eye, follow one eye, follow fellow eye
Case 9